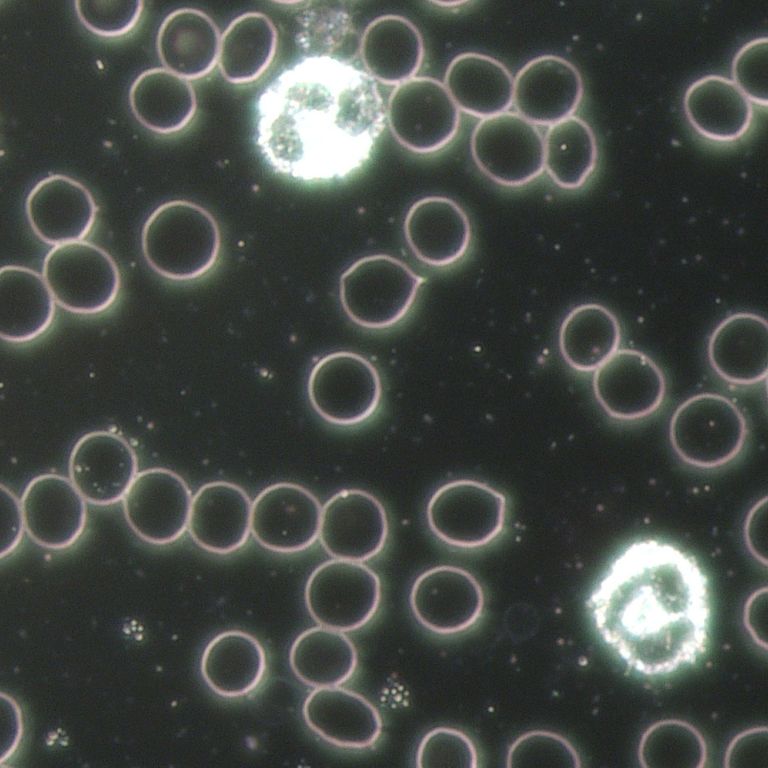

Heidegret Mayer
Heilpraktikerin
Kirchgasse 7
74582 Gerabronn
Tel. 07952/6244
Terminvergabe & Beratung
Montag bis Freitag 7.30 Uhr bis 8.00 Uhr
Montag bis Donnerstag 13.30 bis 14.00 Uhr
Bitte rufen Sie außerhalb dieser Zeiten nur in dringenden Notfällen an!


Meine Behandlungsphilosophie
Heidegret Mayer
• Heilpraktikerin in Gerabronn
• geboren und aufgewachsen in Hohenlohe
• verheiratet, 3 Kinder, 5 Enkel
• seit 1982 in eigener Naturheilpraxis tätig
Meine Schwerpunkte der Diagnostik sind die Dunkelfeld-Mikroskopie, manuelle Untersuchung, Schnelltests, Sono und der Blick der erfahrenen Therapeutin
Meine therapeutischen Schwerpunkte sind
- Neuraltherapie (Injektionen bei akuten und chronischen Schmerzen zur Blockadelösung)
- Osteopathie (manuelle Diagnose und Behandlung zur Autoregulation des Organismus)
- Akkupunktur (Setzten von Nadeln in besondere Hautareale zur Stimulierung einer gesundenden Reaktion des Körpers)
- Homöopathie („Ähnliches durch Ähnliches heilen“ nach Dr. Hahnemann, in Form von Kügelchen, Tropfen, Injektionen, Pulver aus Pflanzen, Mineralien)
- Phytotherapie (rein Pflanzliche Arzneien)
- Anthroposophische Medizin
- Systemische-Therapie/Familien-Therapie
Dies alles mit Freude und Interesse am Menschen, an deren Biografien und Lebensumständen und mit dem Willen, ihr ganz individuelles Leiden zu lindern.
Dunkelfeld-Mikroskopie: Die Untersuchung des Blutes unter dem Mikroskop eröffnet die Möglichkeit Allergien, Infektionen, Stoffwechselstörungen, Gerinnungsstörungen und Autoimmunerkrankungen zu erkennen. Da nur ein Tropfen Blut benötigt wird, ist diese Untersuchung auch gut bei kleinen Kindern möglich.

Verbandstätigkeit
Mitglied und zertifiziert bei
ACON – Arbeitsgemeinschaft Chiropraktik-Osteopathie-Neuraltherapie
AGAHP – Arbeitsgemeinschaft Anthroposophischer Heilpraktiker
FDH – Fachverband Deutscher Heilpraktiker
Ständige Teilnahme an Fortbildungen, Zertifizierungen und Mitarbeit auch auf Forschungsebene.




Vortragstätigkeit bei Volkshochschulen, Vereinen, Arbeitskreisen und KollegInnen
Vortragstitel:
- Gürtelrose – nervig ohne Ende?
- Wenn’s kracht im Gebälk – Osteoporose
- Immunsystem – mit gesunder Abwehr durchs ganze Leben
- Cholesterin und Bluthochdruck – die so genannten Risikofaktoren
- Die biologische Haus-Apotheke
- Tinnitus – Der Mann im Ohr?
- Jetzt schlägt’s 13 – Schlaganfall
- Alarm im Darm
- Schüssler Salze in gesunden und kranken Tagen
- Schüssler Salze für Fortgeschrittene
- Borreliose – die mysteriöse Krankheit
- Schmerzen – der Wachhund des Körpers
- Wechseljahre – Zeiten des Wechsels
- Das Säure-Basen-Gleichgewicht
- Krebserkrankungen – Erkrankungen unserer Zeit
- Mit Haut und Haar....
- Homöopathie – über 200 Jahre alt und immer noch jung
- Blut ist ein ganz besonderer Saft
- Hausapotheke für Kinder
- Arthrose – Wenn Bewegung schmerzt
Durch meine langjährige Erfahrung in der eigener Praxis vermittle ich die Themen sehr anschaulich und kompetent. Außerdem: Eine Dosis Humor darf dabei auch nicht fehlen…

